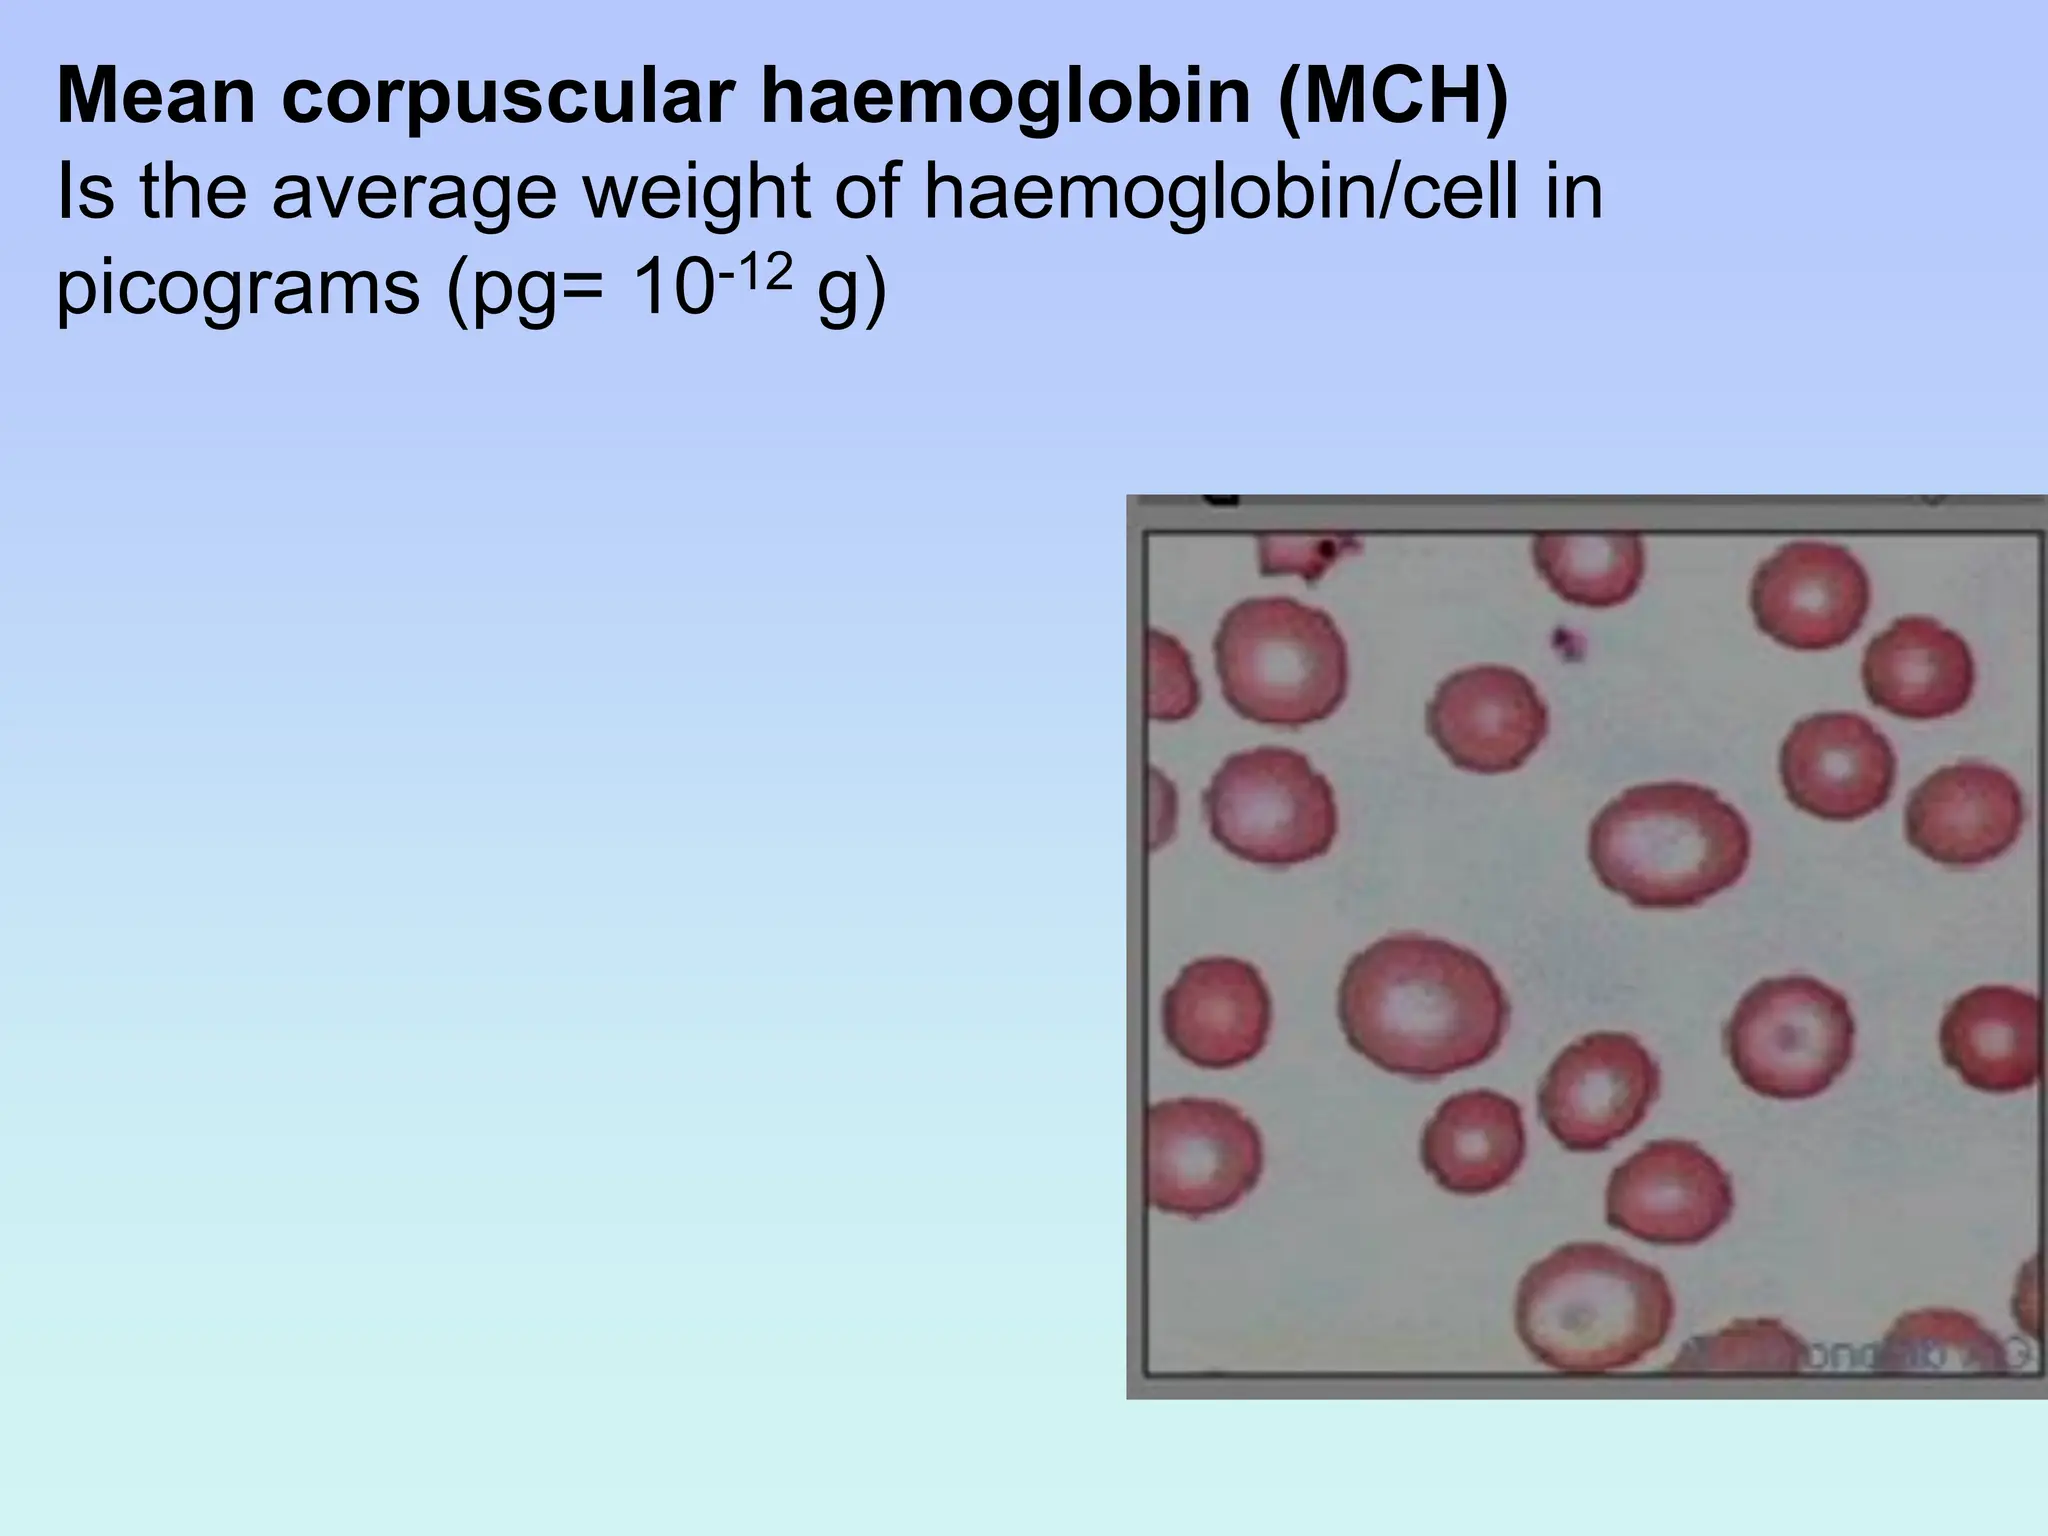
Mean corpuscular haemoglobin (MCH)
Is the average weight of haemoglobin/cell in
picograms (pg= 10-12 g)
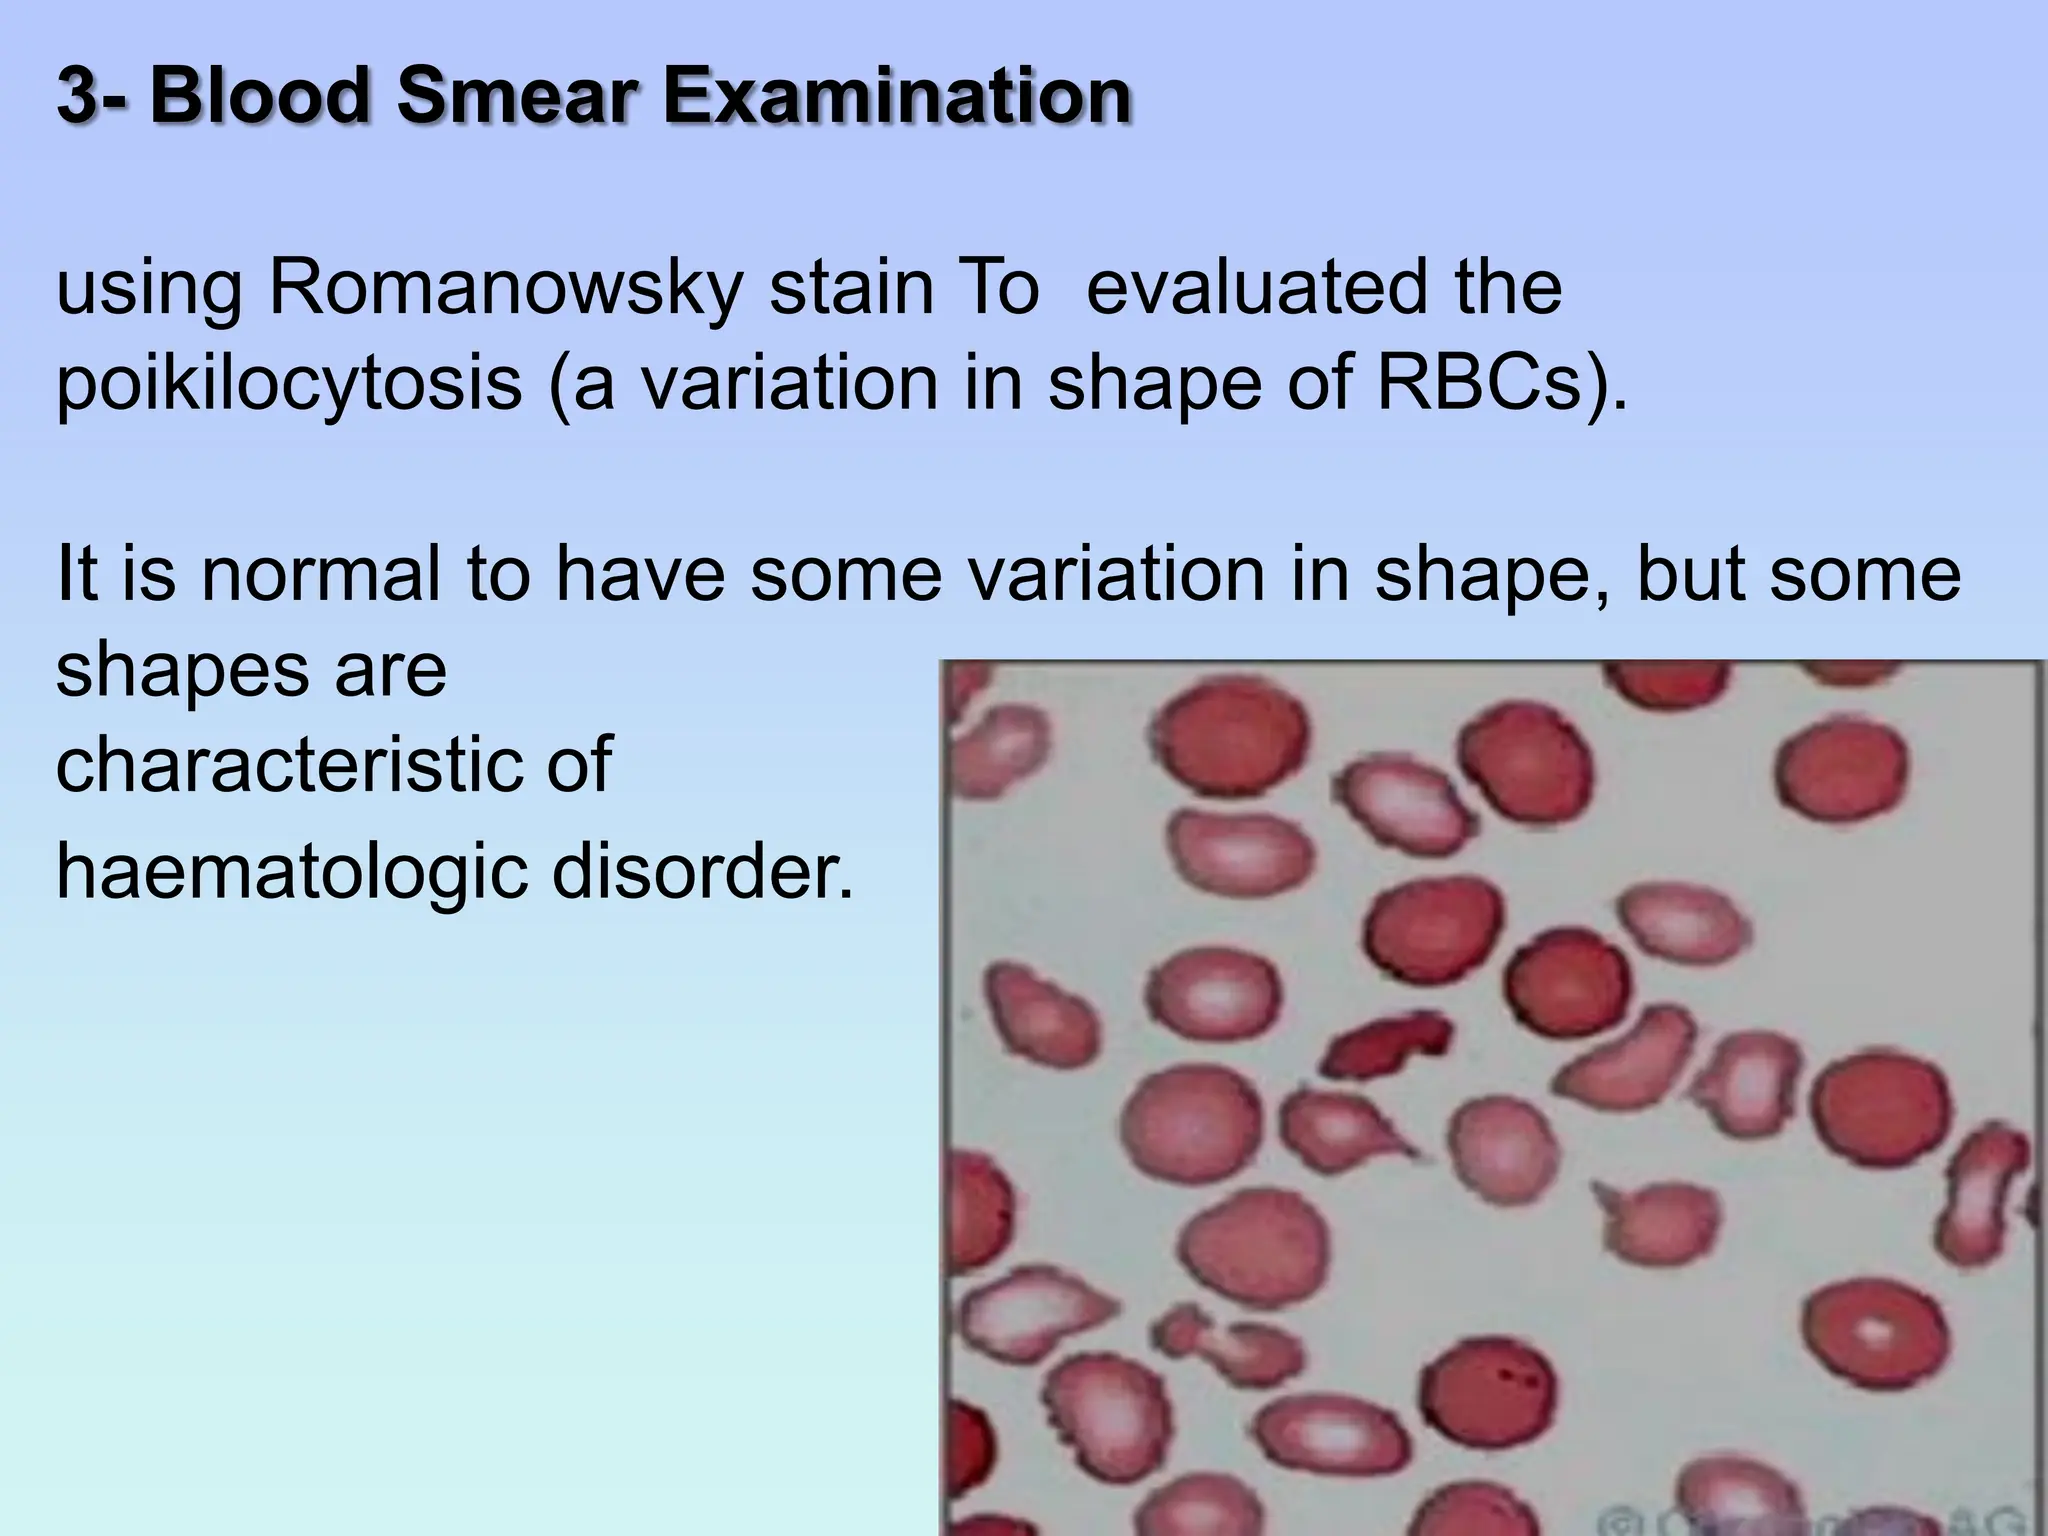
3- Blood Smear Examination
using Romanowsky stain To evaluated the
poikilocytosis (a variation in shape of RBCs).
It is normal to have some variation in shape, but some
shapes are
characteristic of
haematologic disorder.

This document provides a comprehensive overview of anemia, detailing its definition, classification, symptoms, and diagnostic approaches. Anemia is characterized by a reduction in hemoglobin concentration, with causes classified morphologically, functionally, and etiologically. Key laboratory investigations include complete blood counts and reticulocyte counts to determine underlying causes and guide treatment.